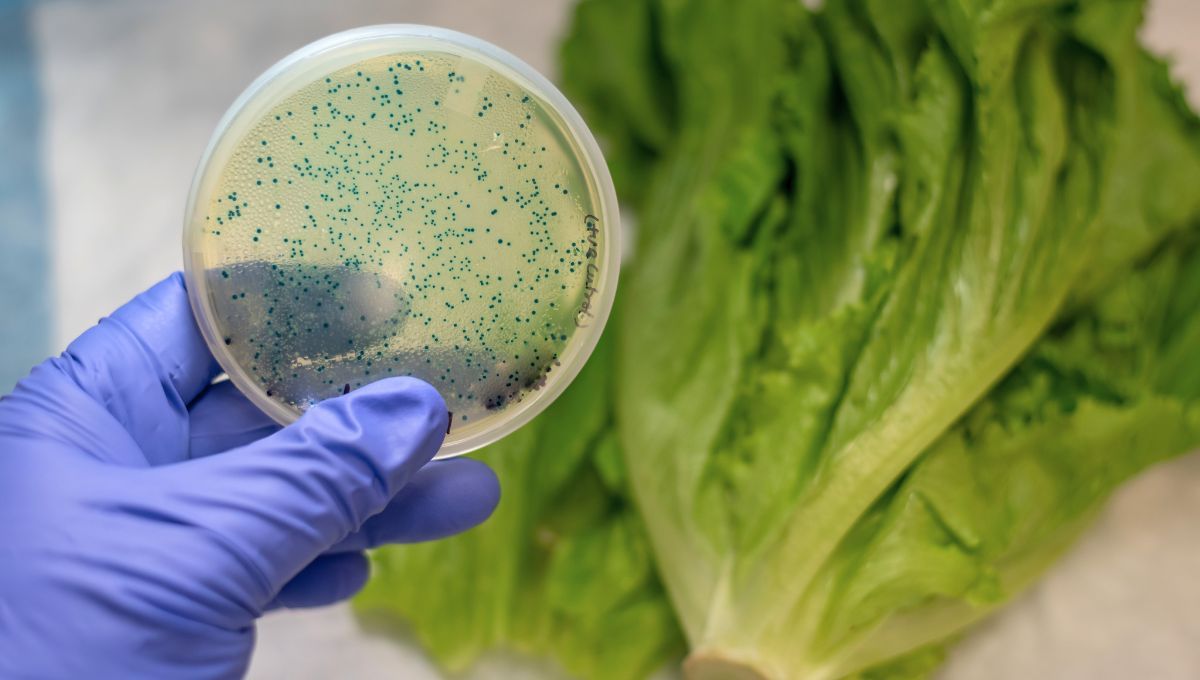
Las enfermedades causadas por alimentos afectan directamente el sistema digestivo. Las enfermedades causadas por alimentos afectan directamente el sistema digestivo.

Es una realidad, no un invento ni una regla molesta que debas infravalorar. Cuando se trata de alimentos, existen varios errores de cocina que pueden desatar un problemón si no se evitan a tiempo.
Uno de los errores más comunes que se produce por desconocimiento o creencia de que "no es para tanto" es el corte de alimentos en tablas de picar no diferenciadas. Seguro alguna vez has cortado la carne en una tabla y en ese mismo plástico las verduras crudas o vegetales cocidos. Te cuento por qué no deberías hacerlo.
En Argentina existen diversos manuales de "buenas prácticas de manufactura", códigos alimentarios para las industrias y guías de casa para mantener los alimentos que comemos seguros.
¿Por qué es peligroso cortar alimentos animales y vegetales en la misma tabla?
Cortar carne cruda en la misma tabla que cortamos verduras, sin realizar ninguna desinfección en el medio, es el motivo más frecuente y clásico de contaminación cruzada.
Para entender los peligros de esto, hay que recurrir a la química y a la composición propia de los alimentos. La carne cruda contiene bacterias como la salmonella o la E. coli que se mueren recién cuando entran en contacto con el calor de la cocción.
Si cortamos carne y verdura juntas en una misma tabla, se produce una transferencia de bacterias de la carne a las verduras crudas. Al comer estas verduras crudas (que no pasan por el fuego) las bacterias entran vivas en el organismo y pueden generar una enfermedad de transmisión alimentaria.
En Argentina.gob.ar, en información de interés para la salud, se especifica que las ETA o enfermedades de transmisión alimentaria son provocadas por el consumo de agua o alimentos contaminados con microorganismos o parásitos, o bien por las sustancias tóxicas que aquellos producen.
¿Qué es la contaminación cruzada de los alimentos?
La contaminación cruzada es el proceso por el cual microbios, sustancias químicas o alérgenos se trasladan de un objeto o alimento contaminado a otro que está limpio o listo para el consumo.
Se puede dar contaminación directa de alimentos cuando un alimento contaminado entra en contacto físico con uno que no lo está. Por ejemplo, si la sangre de la carne cruda se toca con una lechuga, al chorrear en la heladera.
Pero también se puede dar de forma indirecta cuando hay un utensilio de por medio. Este sería el caso del uso de la misma tabla o el mismo cuchillo para cortar alimentos crudos de diferente origen.
¿Cuál es la solución a este problema de alimentos?
Puedes hacer dos cosas para prevenir la contaminación cruzada. Lo ideal es tener tablas de alimentos diferentes para cortar carne y verduras por separado. Las tablas de vidrio templado son las mejores.
Si esto no es posible, lo que tienes que hacer es cortar primero las verduras en la tabla, ponerlas en una compotera limpia hasta usarlas, desinfectar la tabla, cortar la carne y volver a desinfectarla con un poco de lavandina en gel hasta el siguiente uso.